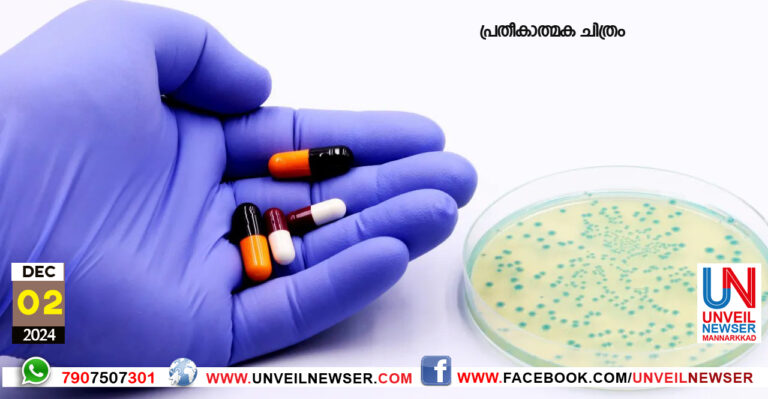
ANTIBIOGRAM

പാലക്കാട് : കേരള സംസ്ഥാന ന്യൂനപക്ഷ കമ്മീഷന് അംഗമായ പി. റോസയുടെ നേതൃ ത്വത്തില് പാലക്കാട് കളക്ടറേറ്റ് കോണ്ഫ്രന്സ്...
Month: December 2024
അലനല്ലൂര് : എം.എല്.എയുടെ പ്രാദേശിക വികസന ഫണ്ട് ഉപയോഗിച്ച് നിര്മിച്ച അലന ല്ലൂര് പഞ്ചായത്തിലെ പെരിമ്പടാരി ഞരളം അംഗനവാടി...
തെങ്കര : വേനല്ക്കാലത്ത് പുഴയോരത്ത് കുഴികുത്തി ശുദ്ധജലം ശേഖരിച്ചതൊക്കെ തെങ്കര ആനമൂളി ഗോത്രഗ്രാമത്തിലുള്ളവര്ക്ക് ഇനി പഴയകഥയാണ്. വീടുകളിലേക്ക് പൈപ്പുവഴി...
രാജ്യത്ത് ആദ്യമായി ആന്റി ബയോഗ്രാം മൂന്നാം തവണയും പുറത്തിറക്കി മണ്ണാര്ക്കാട് : കേരളത്തിലെ ആന്റി മൈക്രോബിയൽ റെസിസ്റ്റൻസ് (എഎംആർ)...
മണ്ണാര്ക്കാട് : താലൂക്കില് ഇതുവരെ മസ്റ്ററിങ് ചെയ്യാത്ത മുന്ഗണനാ കാര്ഡുകളിലെ (എ.എ.വൈ, പി.എച്ച്.എച്ച്) അംഗങ്ങള്ക്ക് മസ്റ്ററിങ് നടത്തുന്നതിന് ഡിസംബര്...
തച്ചമ്പാറ: കെ.എസ്.ടി.എ. അധ്യാപക ജില്ലാ കലോത്സവം ഡിസംബര് 14ന് തച്ചമ്പാറ ദേശബന്ധു ഹയര് സെക്കന്ഡറി സ്കൂളില് നടക്കും. 12...
കോട്ടോപ്പാടം : പുറ്റാനിക്കാട് സന്തോഷ് ലൈബ്രറി ആന്ഡ് റിക്രിയേഷന് സെന്ററിന് കീഴില് വയോജനവേദി രൂപീകരിച്ചു. താലൂക്ക് ലൈബ്രറി കൗണ്സില്...
മണ്ണാര്ക്കാട് : കേരള സംസ്ഥാന ഐ.ടി. മിഷന്റെ പദ്ധതിയായ ഇ-ഡിസ്ട്രിക്ട് പോ ര്ട്ടലിലെ സേവനങ്ങള് പ്രയോജനപ്പെടുത്തുന്നതിന് യൂസര് അക്കൗണ്ട്...
അലനല്ലൂര് : പടിക്കപ്പാടം വാര്ഡ് വനിതാലീഗ് കണ്വെന്ഷന് പടിക്കപ്പാടം മദ്റസാ ഹാളില് നടന്നു. എടത്തനാട്ടുകര മേഖല കമ്മിറ്റി സംഘടിപ്പിക്കുന്ന...
കുമരംപുത്തൂര് : കുമരംപുത്തൂര് ഗ്രാമീണ് വനിതാ ഇന്സ്റ്റിറ്റിയൂഷനില് വനിതകള് ക്കായി നടത്തുന്ന കംപ്യൂട്ടര്, തയ്യല് പരിശീലന കോഴ്സിലേക്ക് അപേക്ഷ...